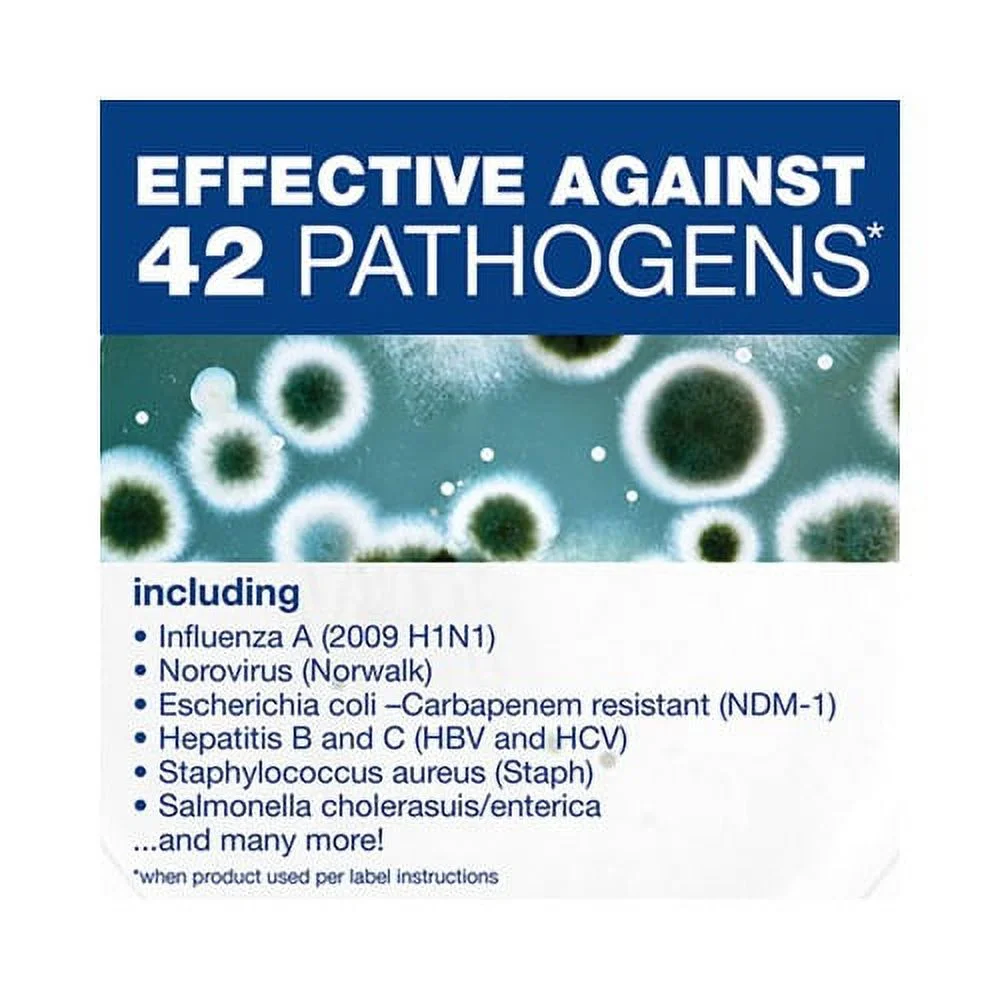
Disinfecting Cleaner with Bleach 1 gal Bottle

Home
/
Product1
Product1
Clear all


68%
OFF
QUICK VIEW
VitaMax Pro Daily Multivitamin™ - Vit A, B6, B12, C, D3, E and more.
$ 34.95
Save
$ 24.06


72%
OFF
QUICK VIEW
Airborne Orange Flavored Gummies,1000mg of Vitamin C and Minerals & Herbs Immune Support 42 ea (Pack of 4)
$ 55.88
Save
$ 40.39


75%
OFF
QUICK VIEW
Snuggle SuperCare Fabric Softener Dryer Sheets, Lilies and Linen, 200 Count
$ 26.34
Save
$ 19.85

70%
OFF
QUICK VIEW
Nutri-Supreme Research Kosher Theanine Supreme - 90 Capsules
$ 26.44
Save
$ 18.75


72%
OFF
QUICK VIEW
GTMEDIA Monitor,Portable Display IPS 173 Built-in Portable Built-in Portable Display 173 Monitor 17.3'' ICHU Monitor 7.3'' IPS Screen Monitor 7.3'' QHD Screen *1+Type-C*2 Built-in * 1440(2.5K) IPS
$ 244.79
Save
$ 176.90


72%
OFF
QUICK VIEW
Nature s Nutri-Care Kids Gummy Vitamins - Kid Multivitamin Gummies with Vitamin C & D, Folate & Zinc Vitamins for Immunity Support, Grow & Gain Toddler Smart Focus, Chewable Vitamin Gummy for Children
$ 27.23
Save
$ 19.74

![The common cabbage worm in Wisconsin (Pontia rapae Linn.) / H.F. Wilson. Volume v.45(1919) 1919 [Leather Bound]](https://cdn.febdovoimage.com/uploads/188890/cart/resources/20251224/9B07D2AC-38EB-81DF-84B6-70DB41F2BBC1.jpg)
![The common cabbage worm in Wisconsin (Pontia rapae Linn.) / H.F. Wilson. Volume v.45(1919) 1919 [Leather Bound]](https://cdn.febdovoimage.com/uploads/188890/cart/resources/20251224/B96044DA-8190-D67C-E97E-B2A9C351E11B.jpg)










